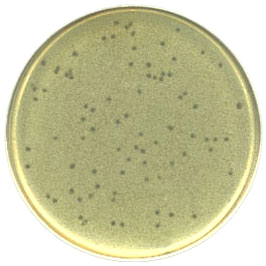

Lambda Phage Plaques
This is what phage look like when grown on a lawn of bacteria.
Phage lyse the white-ish bacteria and leave a "whole" that appears darker.

http://www-micro.msb.le.ac.uk/LabWork/bug/bug3.htm
Molecular Biology Main Page
Course Materials
Biology Main Page


© Copyright 2005 Department of Biology, Davidson College,
Davidson, NC 28035
Send comments, questions, and suggestions to: macampbell@davidson.edu